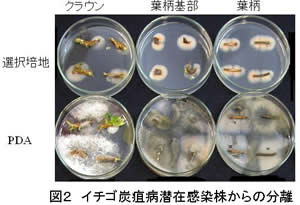

| [成果情報名] | 選択培地によるイチゴ炭疽病菌の潜在感染株および培養土における動態解析 |
| [要約] | ベノミル剤耐性菌を対象に作製した選択培地により潜在感染株や鉢土から炭疽病菌が分離できる。潜在感染株は外側葉位の小葉や葉柄、葉柄基部から炭疽病菌が高率に分離され、内側葉位になるほど低下する。炭疽病菌の分生子は培養土で生存し、感染源となる。 |
| [キーワード] | イチゴ、炭疽病、Glomerella cingulata、選択培地、伝染源 |
| [担当] | 奈良農総セ・研究開発部 |
| [連絡先] | 電話 0744-22-6201、電子メールokayama@naranougi.jp |
| [区分] | 近畿中国四国農業・生産環境(病害虫) |
| [分類] | 研究・普及 |
[具体的データ]

|
 |
| [その他] | ||
| 研究課題名 | : | イチゴ炭疽病潜在感染と薬剤耐性菌の迅速同時診断技術の開発 |
| 予算区分 | : | 農林水産研究高度化事業 |
| 研究期間 | : | 2006〜2007年度 |
| 研究担当者 | : | 岡山健夫、平山喜彦、西崎仁博 |
| 発表論文等 | : | 1)岡山ら(2007)日植病報73(3):155−161. 2)岡山健夫(2008)植物防疫62(3):140−143. |